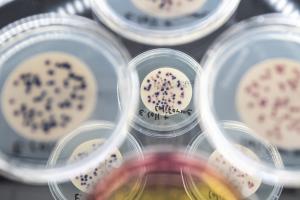
2110_hygieneinstitut-9668.jpg

Umstellung auf digitalen Versand von Berichten und Rechnungen21.12.2023
Als Unternehmen, das sich seiner Verantwortung gegenüber der Umwelt bewusst ist, setzen wir uns aktiv für den Umweltschutz, Ressourcenschonung und -einsparungen ein. Aus diesem Grund möchten wir Sie darüber informieren, dass wir ab dem 01.01.2024 durch die Einführung der elektronischen Freigabe eine Modernisierung unseres Dokumentenversands vornehmen werden. Unsere AGB wurden ebenfalls entsprechend angepasst (digitale Freigabe; AGB 10.4).
Um den Papier-, Toner und Energieverbrauch zu reduzieren und unseren ökologischen Fußabdruck zu minimieren, werden wir nach langer, intensiver und gründlicher Vorbereitungsphase somit den Versand von Berichten und Rechnungen auf eine digitale Form umstellen. Das bedeutet, dass zukünftig alle Berichte und Rechnungen per E-Mail an Sie versendet werden können. Wir sind überzeugt, dass diese Maßnahme nicht nur dazu beitragen wird, unsere Umwelt zu schützen, sondern auch unsere Prozesse sicherer, zeitgemäßer und flexibler zu gestalten, um Ihnen mit einer effizienteren und zeitnahen Bearbeitung Ihrer Aufträge und Kommunikation einen noch besseren Service bieten zu können.
Wie geht es jetzt weiter?
Die Einführung dieses Prozesses wurde begonnen und wird nun sukzessive in allen Abteilungen umgesetzt. Für bereits umgestellte Prozesse bedeutet dies, dass ab dem genannten Datum ein elektronisch signiertes PDF-Dokument zur Verfügung gestellt wird und der bisher übliche Versand von Papier-Dokumenten mit Unterschrift entfällt.
Diese Änderung betrifft ausschließlich Neuaufträge bzw. bei Daueraufträgen und Rahmenverträgen die Ergebnismitteilung zur nächsten Probennahme nach Umsetzung der digitalen Freigabe in der jeweiligen Abteilung.
Für eine zusätzliche, gedruckte Fassung unserer Berichte erheben wir ab dann eine Gebühr als reine Aufwandsentschädigung. Sie können dies bei Bedarf als Zusatzleistung mit beauftragen. Sollte der Wunsch nach einem Papier-Exemplar erst nach der Auftragserteilung entstehen, werden wir diesem selbstverständlich ebenfalls nachkommen, indem wir ein separates Angebot mit den zusätzlichen Kosten erstellen.
Um Ihnen eine bessere Orientierung zu bieten, werden ab dem 01.01.2024 Informationen über diese Änderung im Dokumentenversand in neu erstellte Angebote und Auftragsbestätigungen integriert. Falls Ihre Anfrage ab dem 01.01.2024 von dieser Umstellung noch nicht betroffen ist, werden die Ergebnisberichte trotz der Information auf Angebot und Auftragsbestätigung weiterhin postalisch versendet und keine zusätzlichen Kosten für Sie anfallen.
Für bestehende Aufträge ändert sich nichts
Für alle bereits umgestellten Prozesse gilt: Alle Aufträge, die vor dem Umstellungsdatum eingegangen sind, werden wie gewohnt mit einem gedruckten Ergebnisbericht abgeschlossen, der in diesem Fall selbstverständlich kostenfrei für Sie ist. Auf Wunsch können Sie aber selbstverständlich bereits jetzt auf unser digitales Freigabeverfahren umstellen
Wir streben selbstverständlich an, ein einheitliches System für Sie zu schaffen. Daher planen wir, bis zum 01.06.2024 alle Prozesse auf die digitale Freigabe umgestellt zu haben.
Wir sind überzeugt, dass diese Umstellung die Qualität unserer Dienstleistungen weiter verbessern wird. Sollten Sie Fragen oder Bedenken bezüglich dieser Änderung haben, stehen wir Ihnen gerne zur Verfügung. Unser Team ist für Sie da, um Ihre Anliegen zu klären und Sie ggf. bei der Umstellung zu unterstützen.
Wir danken Ihnen herzlich für Ihr Verständnis und Ihre Zusammenarbeit bei diesem wichtigen Schritt zum Schutz unserer Umwelt und Ressourcen. Gemeinsam können wir einen positiven Einfluss auf die Umwelt ausüben und einen nachhaltigeren Weg in die Zukunft einschlagen!








.png)

.jpg)





.png)

.png)
.png)

.jpg)


.png)
.png)

.png)